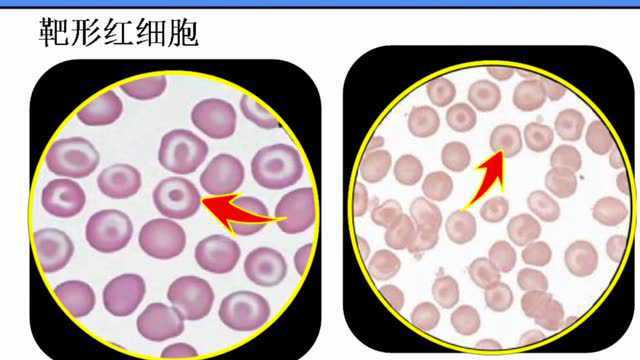
血细胞的显微镜检查_腾讯视频
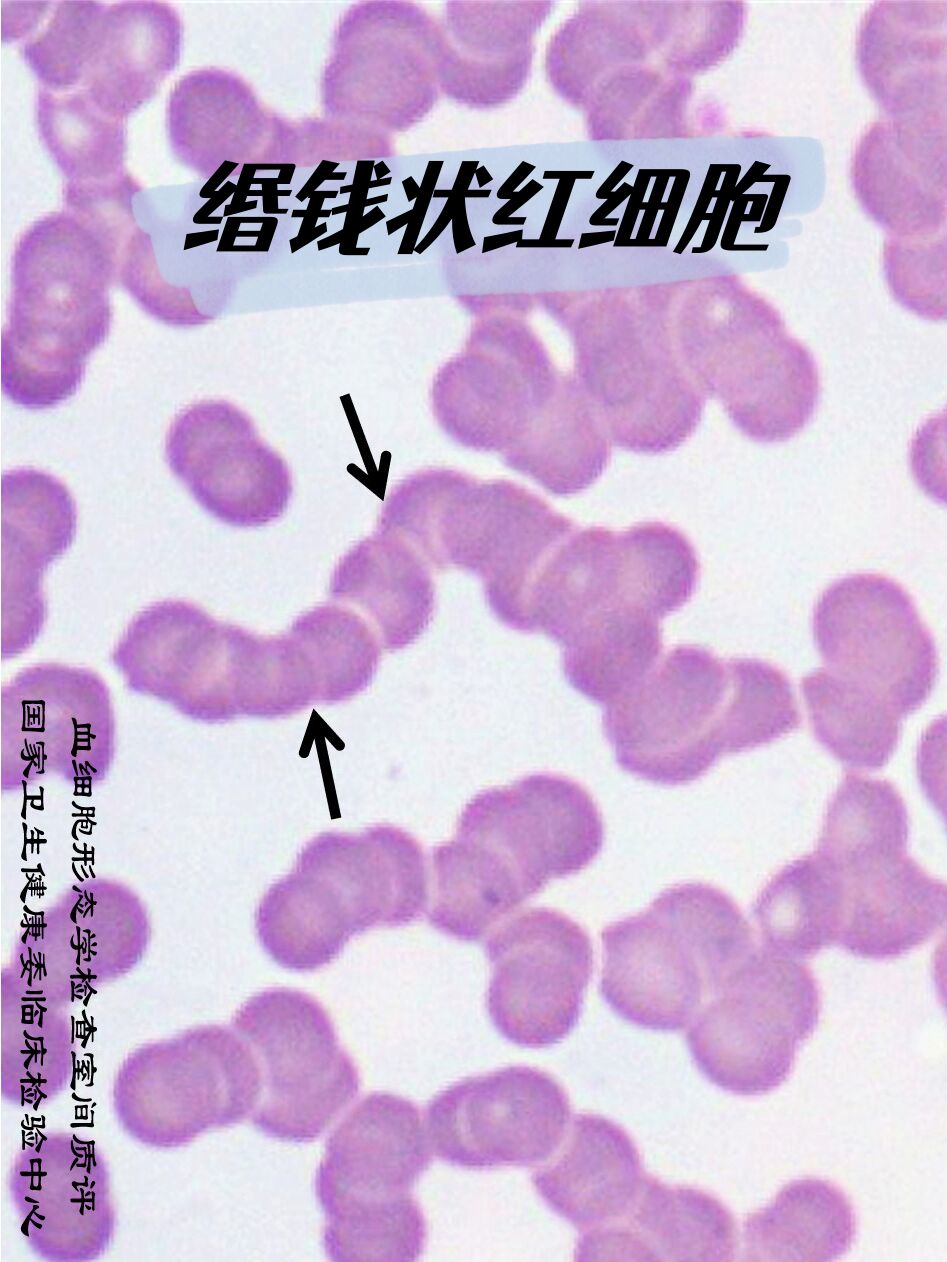
缗钱状红细胞|靶形红细胞|豪焦小体 9792缗钱状红细胞:红细胞缗钱

靶形红细胞图片

靶形红细胞
图片尺寸421x310
卫健委临检中心2020年血细胞形态学检查室间质量评价及答案|红细胞
图片尺寸650x474
靶形红细胞的注意事项
图片尺寸306x231
54%,coombs试验阴性,红细胞cd55百分比0.26,红细胞cd59百分比0.
图片尺寸396x297
缗钱状红细胞|靶形红细胞|豪焦小体 97 92缗钱状红细胞:红细胞缗
图片尺寸524x699
区中心医院的夏万宝老师分享的10张外周血图片 写美篇2,靶形红细胞 3
图片尺寸799x526
靶型红细胞
图片尺寸1080x810
▼「靶形红细胞」形态特征:细胞中央深染,外围苍白,边缘又深染,呈靶状
图片尺寸750x562
一例冷凝集引起的血常规结果异常
图片尺寸750x1000
血细胞的显微镜检查_腾讯视频
图片尺寸640x360
「流泪」的红细胞,你注意了吗?_医学界-助力医生临床决策和职业成长
图片尺寸824x704
body)请报告箭头所指细胞内结构的名称2017103棘形红细胞请报告箭头所
图片尺寸828x676
3,可见红细胞大小不均,以小红细胞为主,可见少量靶形红细胞(绿色箭头)
图片尺寸660x615
溶血|红细胞|血细胞|血常规|hba1c_网易订阅
图片尺寸660x674
缗钱状红细胞|靶形红细胞|豪焦小体 9792缗钱状红细胞:红细胞缗钱
图片尺寸947x1262
图4箭头所示为两个靶形红细胞(瑞姬氏染色 ×1000)心得体会地中海贫血
图片尺寸768x576
血常规小贴士⑦红细胞
图片尺寸589x341
那些年曾经被混淆过的红细胞
图片尺寸634x486
请报告箭头所指细胞名称点击空白处查看答案靶形红细胞外周血涂片,瑞
图片尺寸1080x823
再看一下骨髓红细胞形态也是有问题的哦,不过靶形红细胞没有血片明显
图片尺寸560x465